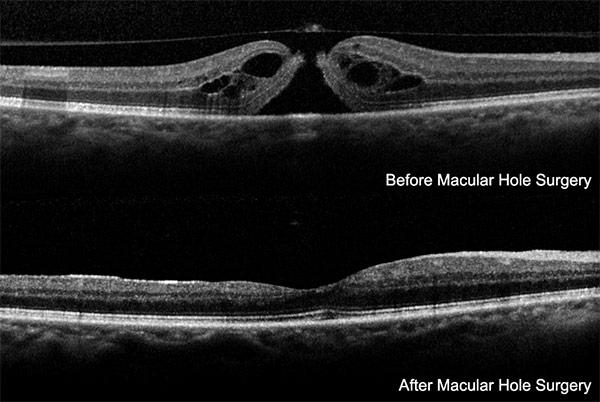

Description
The Downtown ophthalmologists and retina specialists at Vitreous Retina Macula Consultants of New
York are internationally known leaders in diagnosing and treating retinal diseases. The VRMNY
retina doctors in the Lower Manhattan are world-recognized retina experts in difficult-to-diagnose
and rare conditions. They offer the latest treatments for retinal diseases, focusing on treating
macular degeneration, diabetic retinopathy, and retinal tears and detachments. This exceptional and
unique expertise, joined with their attentive, empathetic concern and careful approach means that
even expert Manhattan ophthalmologists turn to Downtown Manhattan retina doctors first when they or
their families need care.
VRMNY retina doctors have trained and taught at some of the world's finest and most respected
academic institutions. The physicians who comprise the best retina specialists in New York are
experts in vitrectomy surgery and hold academic appointments at Lenox Hill Hospital, New York
University, and the New York Eye and Ear Infirmary.
Our ophthalmologists in Downtown specialize in treating all medical and surgical retinal conditions,
emphasizing macular degeneration and diabetic retinopathy, the two leading causes of retinal vision
loss.
With state-of-the-art New York ophthalmology center in Downtown , Manhattan, VRMNY is the largest
retina vitreous center in the New York Metropolitan area.
Our Downtown, New York ophthalmologists and eye doctors publish more in the foremost peer-reviewed
journals than any other private or academic group in the United States. The practice devotes its
time and resources to research and developing new diagnostic and therapeutic strategies. Many
current concepts in retinal disease and treatment recognized worldwide were invented at VRMNY.
The attention, empathetic concern, and careful approach of the eye care specialists and their
support team of retina surgeons explain the success of VRMNY. The over 60 member staff provides a
full range of educational, medical, and surgical services. With an emphasis on patient education,
the staff delivers compassionate and empowering care.
For more information about the Vitreous Retina Macula Consultants of New York, our doctors, or to
schedule a consultation with Dr. Lawrence A. Yannuzzi, MD, please contact our ophthalmology practice
by number: 212-234-3367.
Google maps: https://www.google.com/maps?cid=14609644347999706912
https://plus.codes/87G7PX9X+7J New York
Nearby Service Locations:
Tribeca, New York, NY, USA
Gramercy Park, New York, NY, USA
Ukrainian Village, New York, NY, USA
Alphabet City, New York, NY 10009, USA
Lower East Side, New York, NY, USA
Chinatown, New York, NY, USA
Peter Cooper Village, New York, NY, USA
West Village, New York, NY, USA
Bowery, New York, NY, USA
Greenwich Village, New York, NY, USA
East Village, New York, NY, USA
NoHo, New York, NY, USA
Civic Center, New York, NY, USA
Lower Manhattan, New York, NY, USA
Union Square, New York, NY 10003, USA
SoHo, New York, NY, USA
Seaport, New York, NY 10038, USA
Nearby Service Zip Codes:
10012, 10002, 10013, 10278, 10007, 10282, 10279, 10271, 10038, 10005
Vitreous Retina Macula Consultants of New York
110 Lafayette St, Suite 502
New York, NY 10013
Tel: 212-234-3367
Tel: 212-861-9797
Fax: 212-628-0698
EN URL: https://www.vrmny.com/
ES URL: https://www.vrmny.com/es/
https://www.vrmny.com/locations/downtown-manhattan/
Driving Directions To The Vitreous Retina Macula Consultants of New York:
from Manhattan: https://maps.app.goo.gl/fPhBYq6T8YFL5dvR8
from Brooklyn: https://maps.app.goo.gl/Dzdi4at5k94oym9M9
from Queens: https://maps.app.goo.gl/X2Y9uijgPvCiDidQ9
from Jersey City: https://maps.app.goo.gl/TYWQvucm4SQ6MfxbA
from Staten Island: https://maps.app.goo.gl/6BHvF3VRpobahyf59
Keywords
retina specialists,
best retina specialists,
retina doctors,
diabetic retinopathy treatment injection,
diabetic retinopathy treatment,
eye surgeons,
diabetic retinopathy eye injections,
injection in eye for retinopathy,
laser eye surgery nyc,
nyc laser eye surgery,
injection for diabetic retinopathy,
diabetic retinopathy injections,
diabetic retinopathy treatments,
treatment for diabetic retinopathy,
diabetes eye injections,
diabetic eye injections,
retinopathy treatment,
laser eye surgery new york,
eye surgery nyc,
macular edema injection,
eye surgery new york,
laser surgeries,
retinal edema treatment,
diabetic macular edema treatment,
nyc eye doctor,
eye doctor nyc,
best eye exam nyc,
diabetic blindness treatment,
retinal injection for macular degeneration,
best eye surgery for astigmatism,
treatment for wet macular degeneration,
wet macular degeneration treatment,
strabismus correction,
macular degeneration treatment injection,
focal laser ablation,
wet macular degeneration injections,
eye doctor in manhattan,
macula retina vitreous center,
retina vitreous center,
retina associates of new york,
new york ophthalmologist,
laser retinopexy,
best eye doctors.